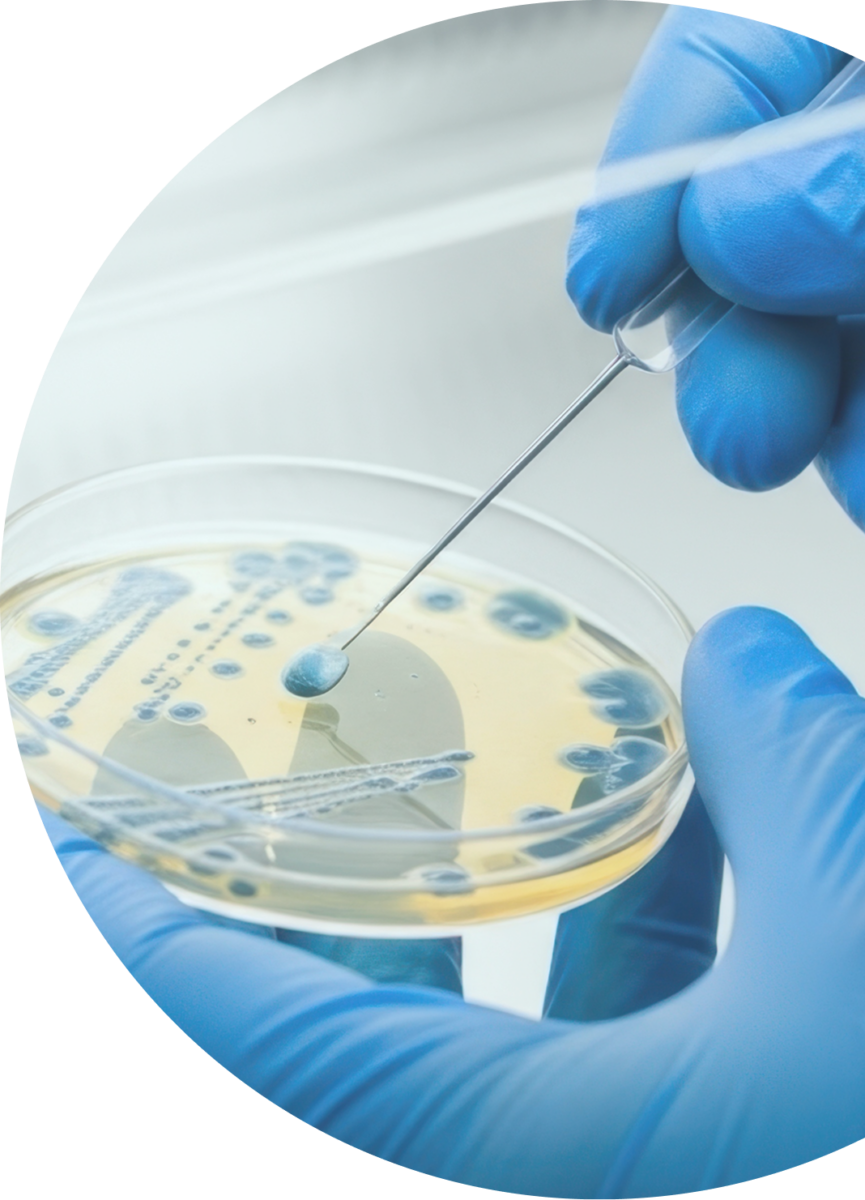

We are a multi-disciplinary team working on drug-resistant infections
Led by Professor Catrin Moore and based at City St George’s, University of London, we focus primarily on the quality and sharing of data and on interventions to reduce the burden of antibiotic resistance (AMR) in common community-acquired diseases such as urinary tract infections.
Our group leads global and regional dialogues around minimising AMR, addressing the use and misuse of antibiotics globally and other interventions especially in low- and middle-income countries.

People
Professor in Global Health and Infectious Diseases
Dr Miriam Nantamu
Senior Research Fellow
Dr Michiyo Iwami
Project Manager
Becky Gathercole
Senior Research Project Manager
Dr Arun Decano
Post-Doctoral Bioinformatician
Setah Alavi
Research Fellow
Millie Williams-Walker
PhD Student
Collaborators
Uganda
Uganda
France
UK
Celine Chui
UK
UK
Sweden
We are working on a number of projects. Most of these are focused on drug-resistant infections specifically relating to UTIs. These include:
Browse projects
ADILA
Lorem ipsum
CAST-UTI
Comparison of community and hospital Antibiotic use practices, Susceptibility and resisTance and determinants of care seeking among patients with Urinary Tract Infections.
This pilot study examines antibiotic resistance in acute urinary tract infections across two socioeconomically diverse Kampala neighbourhoods. The research investigates patients who visit community pharmacies and outpatient clinics, comparing local resistance patterns with WHO Uganda data whilst examining prescribing practices, patient demographics and multi-drug resistance prevalence.
Using phenotypic and genomic techniques, together with social science to understand the patient pathways for treatment. The study aims to establish a framework applicable to other low- and middle-income countries, facilitating intervention strategies to promote appropriate antibiotic use and reduce antimicrobial resistance-related mortality.

Partners: Makerere University, Infectious Disease Research Centre, BioAmp, UTI-lizer
Researchers: To be added
Funder: The Wellcome Trust
Outputs
Lorem ipsum dolor sit amet consectetur. Aliquet sodales quis in purus aliquam eget. Elementum eget ultrices et volutpat ut. Sem leo tristique justo tortor. Mattis in volutpat cras neque molestie pharetra proin. Sed elementum congue ipsum mus felis leo vitae. Enim id luctus in in ridiculus vitae. Iaculis vestibulum nulla amet nulla. Faucibus purus eget cras enim nunc facilisi sollicitudin diam. Nunc elementum pellentesque nunc sed fringilla arcu ut.
CURE
Lorem ipsum
Knocking out AMR
Lorem ipsum
The Fleming fund fellowship in Eswatini
Lorem ipsum
The Fleming fund technical assistance for clinical engagement Africa & Asia
Lorem ipsum
Glossary
ADILA (Antibiotic Data to Inform Local Action)
A previous initiative focused on antimicrobial use surveillance that informed the development of the TACE project
AMR (Antimicrobial Resistance)
When bacteria, viruses, fungi and parasites change over time and no longer respond to medicines, making infections harder to treat
AMU (Antimicrobial Use)
The consumption and prescribing patterns of antimicrobial medicines, including antibiotics
AWaRe
Quality Indicators Assessment tools developed under ADILA to evaluate antibiotic prescribing practices. AWaRe classifies antibiotics as Access, Watch or Reserve based on their importance
CDRO (Community Drug Retail Outlet)
Pharmacies and drug shops in community settings where patients can obtain medicines
CURE (Comprehensive Understanding of Disease and AI Research)
A project using artificial intelligence to harmonise global antimicrobial resistance data
Fleming Fund
An international programme supporting low- and middle-income countries to strengthen antimicrobial resistance surveillance
Fondation Mérieux
An organisation leading consortium work on antimicrobial use in Africa
Genotypic/Genomic techniques
Laboratory methods that analyse the genetic material of bacteria to identify resistance genes
IVI (International Vaccine Institute)
An organisation leading consortium work on antimicrobial use in Asia
LMIC (Low- and Middle-Income Country)
Countries with lower economic development, often facing greater challenges in healthcare infrastructure
Multidrug resistance
When bacteria are resistant to multiple different antibiotics
One Health
An approach recognising that human, animal and environmental health are interconnected
OPD (Outpatient Clinic/Department)
Healthcare facilities where patients receive treatment without being admitted to hospital
Phenotypic techniques
Laboratory methods that test how bacteria respond to antibiotics in practice
Point Prevalence Survey (PPS)
A snapshot assessment of antibiotic use and prescribing practices at a specific point in time
Stewardship
Coordinated programmes to improve appropriate use of antimicrobials, including prescribing practices and treatment guidelines
TACE (Technical Assistance for Clinician Engagement)
A project enhancing antimicrobial use data quality and stewardship in Africa and Asia
UTI (Urinary Tract Infection)
An infection in any part of the urinary system, commonly treated with antibiotics
WHO-GLASS (World Health Organization Global Antimicrobial Resistance and Use Surveillance System)
WHO’s global system for collecting and analysing antimicrobial resistance data to inform policy
Get in touch
Lorem ipsum dolor sit amet consectetur. Ultricies nisi lorem rhoncus eu faucibus.